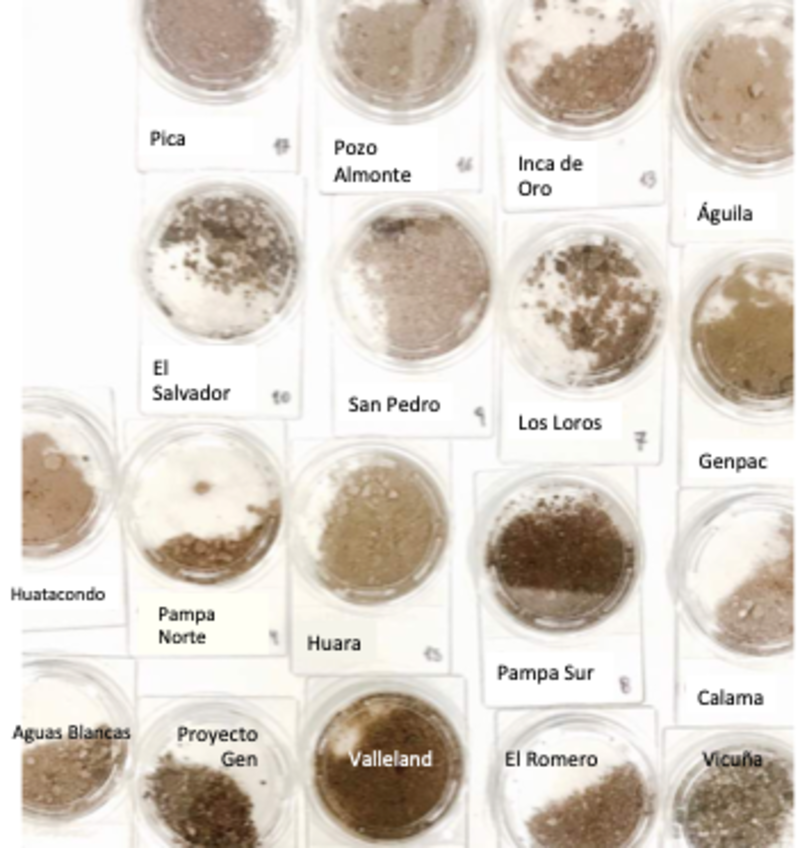

Científicos recorrieron 1.300 km en el desierto de Atacama: descubrieron que el color del suelo indica su potencial solar
Investigadores de la Universidad de Santiago midieron la tonalidad de los suelos del norte de Chile para determinar su influencia y capacidad energética.

Raúl Cordero, climátologo de la U. de Santiago e investigador del grupo científico @AntarcticaCL está acostumbrado a las largas travesías, especialmente en la Antártica, donde pasa largas períodos de tiempo llevando realizando investigaciones. Pero ahora cambió la nieve por la arena. Junto a un grupo de investigadores, recorrió más de 1.300 km del desierto de Atacama, estudiando la capacidad de reflexión de sus arenas.
“Se trató de una nueva gran aventura. Nuestro grupo tiene mucha experiencia en campañas en los lugares más hostiles (como la Antártica), pero también los más hermosos de nuestra geografía. El desierto de Atacama no fue la excepción”.
Gracias a este largo recorrido, el científico pudo realizar un nuevo estudio que midió el color de los suelos del desierto de Atacama, para determinar su influencia y efecto en el rendimiento de un tipo especial de paneles fotovoltaicos. La investigación fue publicada en la revista Scientific Report de Nature.
Cordero dice que a pesar de que en una primera impresión pareciera que todos los desiertos son iguales, el color de los suelos es diferente al comparar un desierto con otro. “Hay suelos más oscuros y hay otros mucho más brillantes. Incluso los del desierto de Atacama presentan considerables variaciones en su color entre una región y otra, o de un sitio a otro”.

El color de las superficies depende de la radiación solar que reflejan, la que a su vez está determinada por su albedo o reflectividad. El albedo es la fracción de la radiación solar reflejada por el suelo. Las superficies blancas, como aquellas cubiertas de nieve, tienen gran albedo o reflectividad porque reflejan más del 90% de la radiación solar incidente. “Por el contrario, los suelos oscuros, como aquellos cubiertos por rocas o por espesa vegetación, tienen bajo albedo porque reflejan una fracción mucho más pequeña de radiación solar que a veces no supera el 5%”, explica el climatólogo.
Cordero señala que el desierto de Atacama es la zona de mayor potencial solar del mundo y a ese potencial contribuyen también sus suelos relativamente brillantes. La radiación solar reflejada por los suelos de los desiertos puede ser aprovechada empleando módulos fotovoltaicos bifaciales, un tipo de panel que tiene celdas solares por ambos lados y por lo mismo, los únicos que aprovechan la radiación reflejada.

Los desiertos tienen gran potencial para la generación de energía solar y a ese potencial contribuye también el alto albedo. El climatólogo dice que este tipo de paneles solares tiene su cara posterior transparente por lo que el silicio está expuesto no solo a la radiación solar incidente, sino también a aquella reflejada por el suelo. Aprovechando la radiación reflejada por el suelo de los desiertos, los módulos bifaciales pueden producir con la misma capacidad instalada un extra de electricidad respecto a los tradicionales paneles fotovoltaicos.
1.300 kilómetros de recorrido y muestras: una gran aventura
El porcentaje de diferencia entre un lugar y otro, como África con América o Europa, ”es el porcentaje de la radiación solar que el suelo refleja. Fuera de los polos, los desiertos, incluido el Desierto de Atacama, son las regiones más brillantes de la Tierra, reflejando entre el 15% y el 35% de la radiación solar incidente. Una excepción es el desierto del Sahara que refleja en algunos puntos casi el 50% de la radiación solar incidente”, señala el académico de la Usach.
Pero incluso en un mismo desierto, el suelo presenta diferentes colores y por lo tanto refleja diferentes cantidades de radiación solar. Enfocado en medir el albedo del desierto de Atacama y determinar como éste podría beneficiar a los módulos bifaciales, Cordero y el grupo de investigadores, recorrió por tierra 1300 km recogiendo muestras de polvo y paralelamente midiendo el albedo de la superficie.
La campaña nos permitió medir las variaciones que el color del suelo del desierto de Atacama presenta entre una región y otra. “Los suelos del desierto en el extremo norte del país son significativamente más brillantes que los suelos al norte de la región de Coquimbo. Estas diferencias regionales tienen que ver con la vegetación que, aunque escasa, limita la cantidad de radiación que el suelo refleja. Los suelos con más vegetación son en promedio más oscuros. Entre los sitios testeados, Huara (Región de Tarapacá) es el mejor para instalar los paneles”, agrega.
Cordero establece que también pudieron determinar las diferencias regionales en los rendimientos esperados de módulos bifaciales. “De acuerdo a nuestros resultados, el desierto de Atacama permitiría a módulos bifaciales generar aproximadamente entre 6% y 12% más electricidad (dependiendo del sitio especifico de instalación) que módulos convencionales de similar capacidad”.
Los resultados también confirman que, en términos de su color, “los suelos del desierto de Atacama son similares a los observados en otras zonas desérticas del mundo como el sur de California, el centro de Australia, o el desierto de Gobi en Asia. Sin embargo, nuestros resultados también confirman que los suelos del desierto de Atacama son mucho mas oscuros que los del desierto del Sahara, la zona no polar más brillante de la Tierra”, señala.
Lea también en Qué Pasa:
COMENTARIOS
Para comentar este artículo debes ser suscriptor.
Lo Último
Lo más leído
2.
Contenidos exclusivos y descuentos especiales
Digital + LT Beneficios$1990/mes por 5 meses SUSCRÍBETE